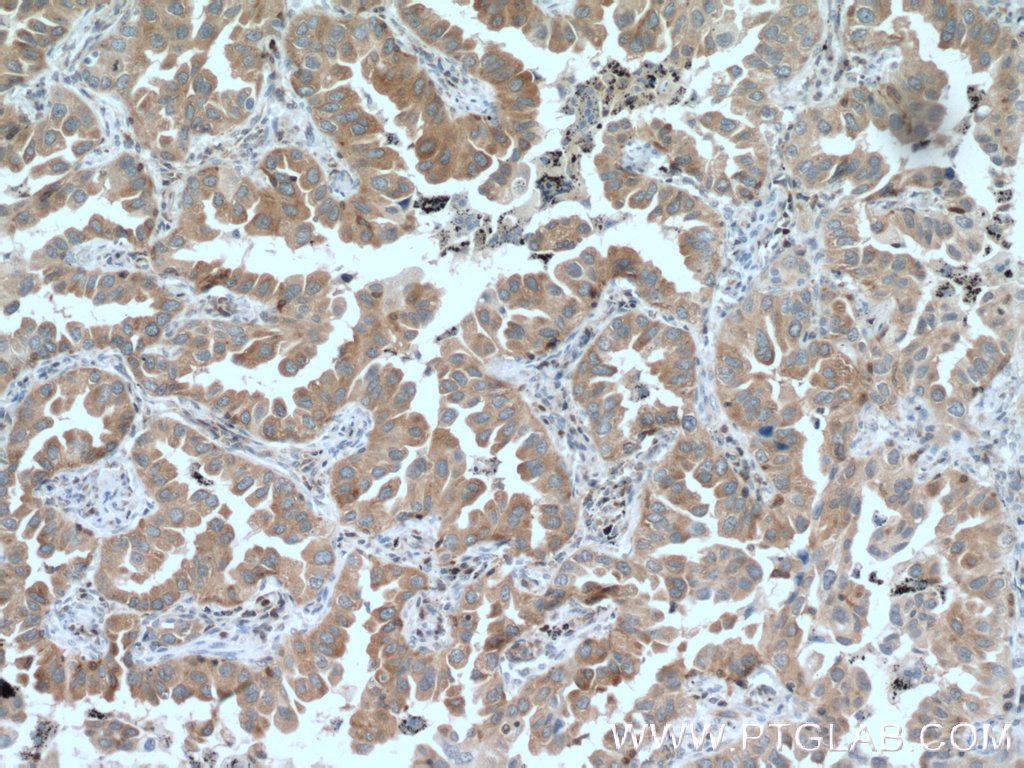

验证数据展示
产品信息
66421-1-PBS targets PKC Alpha in WB, IHC, IF/ICC, FC (Intra), Indirect ELISA applications and shows reactivity with human, mouse, rat samples.
| 经测试应用 | WB, IHC, IF/ICC, FC (Intra), Indirect ELISA Application Description |
| 经测试反应性 | human, mouse, rat |
| 免疫原 |
CatNo: Ag17275 Product name: Recombinant human PRKCA protein Source: e coli.-derived, PGEX-4T Tag: GST Domain: 1-216 aa of BC109274 Sequence: MADVFPGNDSTASQDVANRFARKGALRQKNVHEVKDHKFIARFFKQPTFCSHCTDFIWGFGKQGFQCQVCCFVVHKRCHEFVTFSCPGADKGPDTDDPRSKHKFKIHTYGSPTFCDHCGSLLYGLIHQGMKCDTCDMNVHKQCVINVPSLCGMDHTEKRGRIYLKAEVADEKLHVTVRDAKNLIPMDPNGLSDPYVKLKLIPDPKNESKQKTKTIR 种属同源性预测 |
| 宿主/亚型 | Mouse / IgG1 |
| 抗体类别 | Monoclonal |
| 产品类型 | Antibody |
| 全称 | protein kinase C, alpha |
| 别名 | PRKCA, 1D11F4, AAG6, EC:2.7.11.13, PKC A |
| 观测分子量 | 77 kDa |
| GenBank蛋白编号 | BC109274 |
| 基因名称 | PKC Alpha |
| Gene ID (NCBI) | 5578 |
| RRID | AB_2881793 |
| 偶联类型 | Unconjugated |
| 形式 | Liquid |
| 纯化方式 | Protein G purification |
| UNIPROT ID | P17252 |
| 储存缓冲液 | PBS only, pH 7.3. |
| 储存条件 | Store at -80°C. The product is shipped with ice packs. Upon receipt, store it immediately at -80°C |
背景介绍
Protein kinase C (PKC) is a family of serine- and threonine-specific protein kinases that can be activated by calcium and the second messenger diacylglycerol. PKC family members phosphorylate a wide variety of protein targets and are known to be involved in diverse cellular signaling pathways. PKC family members also serve as major receptors for phorbol esters, a class of tumor promoters. Each member of the PKC family has a specific expression profile and is believed to play a distinct role in cells. PRKCA is one of the PKC family members. This kinase has been reported to play roles in many different cellular processes, such as cell adhesion, cell transformation, cell cycle checkpoint, and cell volume control. Knockout studies in mice suggest that this kinase may be a fundamental regulator of cardiac contractility and Ca(2+) handling in myocytes.